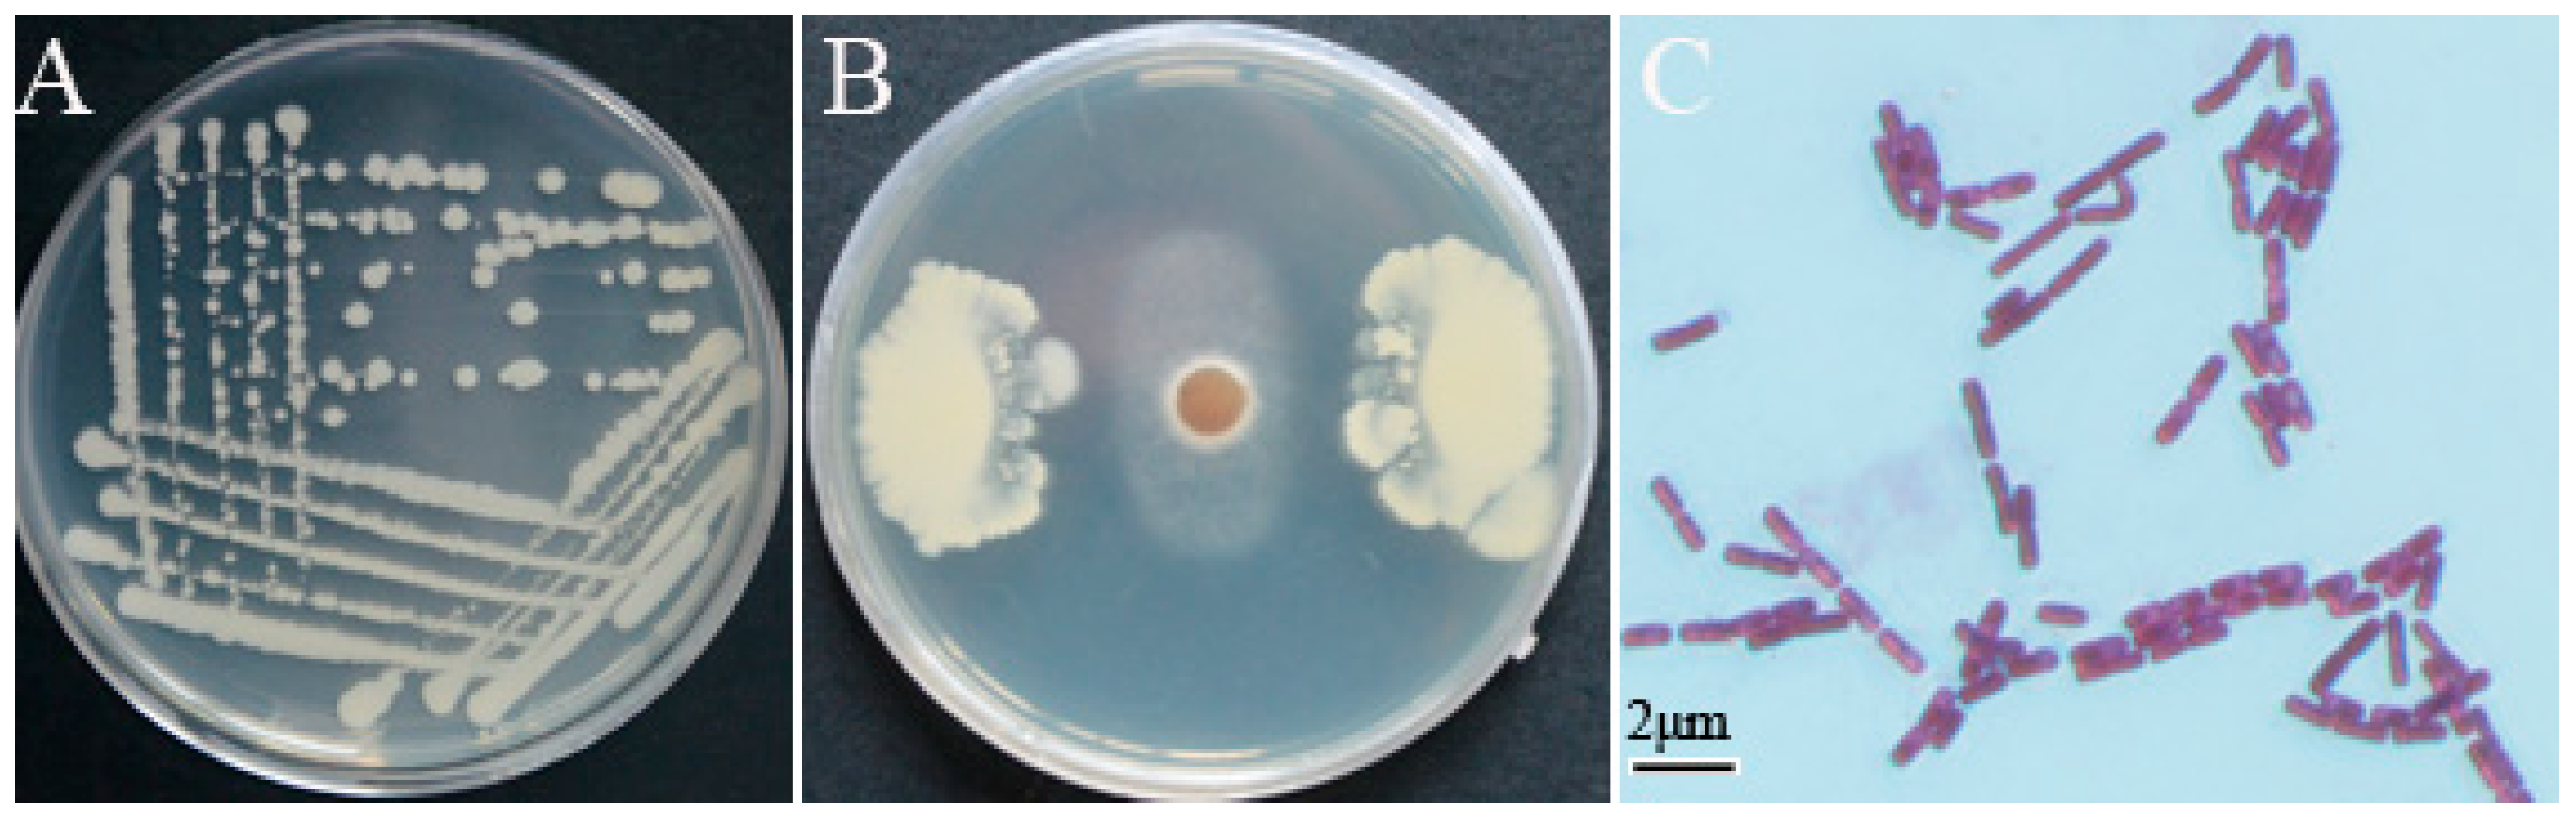
Pathogens 10 00903 g001

Biological Control of Take-All and Growth Promotion in Wheat by Pseudomonas chlororaphis YB-10
Abstract
:1. Introduction
2. Materials and Methods
2.1. Isolation of StrainYB-10
2.2. Identification of Strain YB-10
2.3. Detection of PGP and Antifungal Traits
2.4. Plant Growth Promotion Assay of P. chlororaphis YB-10 on Wheat Seedlings
2.5. Biocontrol Assay of P. chlororaphis YB-10 Against Take-All inWheat
- Seeds soaked with P. chlororaphis YB-10 and not inoculated with Ggt;
- Seeds soaked with P. chlororaphis YB-10 and inoculated with Ggt;
- Seeds not soaked with P. chlororaphis YB-10 and not inoculated with Ggt;
- Seeds not soaked with P. chlororaphis YB-10 and inoculated with Ggt.
2.6. Activities of Defense Enzymes in Wheat Seedlings
2.7. Statistical Analysis
3. Results
3.1. Screening and Identification of Strain YB-10
3.2. Characterization of In Vitro Antifungal and PGP Traits of P. chlororaphis YB-10
3.3. Effect of P. chlororaphis YB-10 Against Take-All in Wheat Seedlings
3.4. Growth Promotion of Wheat Seedlings after P. chlororaphis YB-10 Inoculation
3.5. Effect of P. chlororaphis YB-10 on Activities of Defense Enzymes in Wheat Seedlings
4. Discussion
Author Contributions
Funding
Institutional Review Board Statement
Informed Consent Statement
Data Availability Statement
Conflicts of Interest
References
- Kwak, Y.S.; Weller, D.M. Take-all of Wheat and Natural Disease Suppression: A Review. Plant Pathol. J. 2013, 29, 125–135. [Google Scholar] [CrossRef]
- James, C.R. Take-all of wheat. Physiol. Mol. Plant Pathol. 2003, 62, 73–86. [Google Scholar] [CrossRef]
- Zhang, J.; Yan, H.; Xia, M.; Han, X.; Xie, L.; Goodwin, P.H.; Quan, X.; Sun, R.; Wu, C.; Yang, L. Wheat root transcriptional responses against Gaeumannomycesgraminis var. tritici. Phytopathol. Res. 2020, 2, 1–14. [Google Scholar]
- Gholami, M.; Amini, J.; Abdollahzadeh, J.; Ashengroph, M. Basidiomycetes fungi as biocontrol agents against take-all disease of wheat. Biol. Control 2019, 130, 34–43. [Google Scholar] [CrossRef]
- Yang, L.; Han, X.; Zhang, F.; Goodwin, P.H.; Yang, Y.; Li, J.; Xia, M.; Sun, R.; Jia, B.; Zhang, J.; et al. Screening Bacillus species as biological control agents of Gaeumannomycesgraminis var. Tritici on wheat. Biol. Control 2018, 118, 1–9. [Google Scholar] [CrossRef]
- Bateman, G.L. Prospects for fungicidal control of take-all of wheat. Ann. Appl. Biol. 2010, 96, 275–282. [Google Scholar] [CrossRef]
- Nelson, R.; Wiesner-Hanks, T.; Wisser, R.; Balint-Kurti, P. Navigating complexity to breed disease-resistant crops. Nat. Rev. Genet. 2018, 19, 21–33. [Google Scholar] [CrossRef] [PubMed]
- Woźniak, A.; Soroka, M. Effect of crop rotation and tillage system on the weed infestation and yield of spring wheat and on soil properties. Appl. Ecol. Environ. Res. 2018, 16, 3087–3096. [Google Scholar] [CrossRef]
- Rothrock, C.S. Take-all of wheat as affected by tillage and wheat-soybean doublecropping. Soil Biol. Biochem. 1987, 19, 307–311. [Google Scholar] [CrossRef]
- Bateman, G.L. Progress in research on the control of take-all in cereals with fungicides: A review. Crop. Prot. 1989, 8, 75–81. [Google Scholar] [CrossRef]
- Maplestone, P.A.; Campbell, R. Colonization of roots of wheat seedlings by bacilli proposed as biocontrol agents against take-all. Soil Biol. Biochem. 1989, 21, 543–550. [Google Scholar] [CrossRef]
- Yang, L.; Quan, X.; Xue, B.; Goodwin, P.H.; Lu, S.; Wang, J.; Du, W.; Wu, C. Isolation and identification of Bacillus subtilis strain YB-05 and its antifungal substances showing antagonism against Gaeumannomycesgraminis var. tritici. Biol. Control 2015, 85, 52–58. [Google Scholar] [CrossRef]
- Liu, B.; Qiao, H.; Huang, L.; Buchenauer, H.; Han, Q.; Kang, Z.; Gong, Y. Biological control of take-all in wheat by endophytic Bacillus subtilis E1R-j and potential mode of action. Biol. Control 2009, 49, 277–285. [Google Scholar] [CrossRef]
- Huang, Z.; Bonsall, R.F.; Mavrodi, D.V.; Weller, D.M.; Thomashow, L.S. Transformation of Pseudomonas fluorescens with genes for biosynthesis of phenazine-1-carboxylic acid improves biocontrol of rhizoctonia root rot and in situ antibiotic production. FEMS Microbiol. Ecol. 2004, 49, 243–251. [Google Scholar] [CrossRef] [Green Version]
- Liu, K.; McInroy, J.A.; Hu, C.H.; Kloepper, J.W. Mixtures of Plant-Growth-Promoting Rhizobacteria Enhance Biological Control of Multiple Plant Diseases and Plant-Growth Promotion in the Presence of Pathogens. Plant Dis. 2018, 102, 67–72. [Google Scholar] [CrossRef] [PubMed] [Green Version]
- Hayat, R.; Ali, S.; Amara, U.; Khalid, R.; Ahmed, I. Soil beneficial bacteria and their role in plant growth promotion: A review. Ann. Microbiol. 2010, 60, 579–598. [Google Scholar] [CrossRef]
- Singh, N.; Kumar, S.; Bajpai, V.K.; Dubey, R.C.; Maheshwari, D.K.; Kang, S.C. Biological control of Macrophominaphaseolina by chemotactic fluorescent Pseudomonas aeruginosa PN1 and its plant growth promotory activity in chir-pine. Crop. Prot. 2010, 29, 1142–1147. [Google Scholar] [CrossRef]
- Hernández-León, R.; Rojas-Solís, D.; Contreras-Pérez, M.; del Carmen Orozco-Mosqueda, M. Characterization of the antifungal and plant growth-promoting effects of diffusible and volatile organic compounds produced by Pseudomonas fluorescens strains. Biol. Control 2015, 81, 83–92. [Google Scholar] [CrossRef]
- Santoyo, G.; Orozco-Mosqueda, M.D.C.; Govindappa, M. Mechanisms of biocontrol and plant growth-promoting activity in soil bacterial species of Bacillus and Pseudomonas: A review. Biocontrol Sci. Technol. 2012, 22, 855–872. [Google Scholar] [CrossRef]
- Panpatte, D.G.; Jhala, Y.K.; Shelat, H.N.; Vyas, R.V. Pseudomonas Fluorescens: A Promising Biocontrol Agent and PGPR for Sustainable Agriculture; Springer: New Delhi, India, 2016. [Google Scholar]
- Agaras, B.C.; Noguera, F.; Anta, G.G.; Wall, L.G.; Valverde, C. Biocontrol potential index of pseudomonads, instead of their direct-growth promotion traits, is a predictor of seed inoculation effect on crop productivity under field conditions. Biol. Control 2020, 143, 104209. [Google Scholar] [CrossRef]
- Jain, R.; Pandey, A. A phenazine-1-carboxylic acid producing polyextremophilic Pseudomonas chlororaphis (MCC2693) strain, isolated from mountain ecosystem, possesses biocontrol and plant growth promotion abilities. Microbiol. Res. 2016, 190, 63–71. [Google Scholar] [CrossRef]
- Mazzola, M.; Fujimoto, D.K.; Thomashow, L.S.; Cook, R.J. Variation in Sensitivity of Gaeumannomycesgraminis to Antibiotics Produced by Fluorescent Pseudomonas spp. and Effect on Biological Control of Take-All of Wheat. Appl. Environ. Microbiol. 1995, 61, 2554–2559. [Google Scholar] [CrossRef] [PubMed] [Green Version]
- Kamou, N.N.; Cazorla, F.; Kandylas, G.; Lagopodi, A.L. Induction of defense-related genes in tomato plants after treatments with the biocontrol agents Pseudomonas chlororaphis ToZa7 and Clonostachys rosea IK726. Arch. Microbiol. 2020, 202, 257–267. [Google Scholar] [CrossRef] [PubMed]
- Thomashow, L.S.; Weller, D.M. Role of a phenazine antibiotic from Pseudomonas fluorescens in biological control of Gaeumannomycesgraminis var. tritici. J. Bacteriol. 1988, 170, 3499–3508. [Google Scholar] [CrossRef] [Green Version]
- Lagzian, A.; Saberi Riseh, R.; Khodaygan, P.; Sedaghati, E.; Dashti, H. Introduced Pseudomonas fluorescens VUPf5 as an important biocontrol agent for controlling Gaeumannomycesgraminis var. tritici the causal agent of take-all disease in wheat. Arch. Phytopathol. Plant Prot. 2013, 46, 2104–2116. [Google Scholar] [CrossRef]
- Hariprasad, P.; Chandrashekar, S.; Singh, S.B.; Niranjana, S.R. Mechanisms of plant growth promotion and disease suppression by Pseudomonas aeruginosa strain 2apa. J. Basic Microbiol. 2014, 54, 792–801. [Google Scholar] [CrossRef] [PubMed]
- Vanitha, S.C.; Umesha, S. Pseudomonas fluorescens mediated systemic resistance in tomato is driven through an elevated synthesis of defense enzymes. Biol. Plantarum 2011, 55, 317–322. [Google Scholar] [CrossRef]
- Wang, M.; Zhao, L.; Zhang, X.; Dhanasekaran, S.; Abdelhai, M.H.; Yang, Q.; Jiang, Z.; Zhang, H. Study on biocontrol of postharvest decay of table grapes caused by Penicilliumrubens and the possible resistance mechanisms by Yarrowialipolytica. Biol. Control 2019, 130, 113–117. [Google Scholar] [CrossRef]
- Li, Q.; Li, C.; Li, P.; Zhang, H.; Zhang, X.; Zheng, X.; Yang, Q.; Apaliya, M.T.; Boateng, N.A.S.; Sun, Y. The biocontrol effect of Sporidioboluspararoseus Y16 against postharvest diseases in table grapes caused by Aspergillus niger and the possible mechanisms involved. Biol. Control 2017, 113, 18–25. [Google Scholar] [CrossRef]
- Li, S.M.; Hua, G.G.; Liu, H.X.; Guo, J.H. Analysis of defence enzymes induced by antagonistic bacterium Bacillus subtilis strain AR12 towards Ralstonia solanacearum in tomato. Ann. Microbiol. 2008, 58, 573–578. [Google Scholar] [CrossRef]
- Qin, X.; Xiao, H.; Xue, C.; Yu, Z.; Yang, R.; Cai, Z.; Si, L. Biocontrol of gray mold in grapes with the yeast Hanseniasporauvarum alone and in combination with salicylic acid or sodium bicarbonate. Postharvest Biol. Technol. 2015, 100, 160–167. [Google Scholar] [CrossRef]
- Kumar, S.; Stecher, G.; Tamura, K. MEGA7: Molecular Evolutionary Genetics Analysis Version 7.0 for Bigger Datasets. Mol Biol. Evol. 2016, 33, 1870–1874. [Google Scholar] [CrossRef] [Green Version]
- Glickmann, E.; Dessaux, Y. A critical examination of the specificity of the salkowski reagent for indolic compounds produced by phytopathogenic bacteria. Appl. Environ. Microbiol. 1995, 61, 793–796. [Google Scholar] [CrossRef] [PubMed] [Green Version]
- Schwyn, B.; Neilands, J.B. Universal chemical assay for the detection and determination of siderophores. Anal. Biochem. 1987, 160, 47–56. [Google Scholar] [CrossRef]
- Teather, R.M.; Wood, P.J. Use of Congo red-polysaccharide interactions in enumeration and characterization of cellulolytic bacteria from the bovine rumen. Appl. Environ. Microbiol. 1982, 43, 777–780. [Google Scholar] [CrossRef] [PubMed] [Green Version]
- Kazanas, N. Proteolytic activity of microorganisms isolated from freshwater fish. Appl. Microbiol. 1968, 16, 128–132. [Google Scholar] [CrossRef] [PubMed]
- Wahyudi, A.T.; Astuti, R.I. Screening of Pseudomonas sp. Isolated from Rhizosphere of Soybean Plant as Plant Growth Promoter and Biocontrol Agent. Am. J. Agric. Biol. Sci. 2011, 6, 134–141. [Google Scholar] [CrossRef] [Green Version]
- Gopalakrishnan, S.; Upadhyaya, H.D.; Vadlamud, S. Plant growth-promoting traits of biocontrol potential bacteria isolated from rice rhizosphere. Springerplus 2012, 1, 1–7. [Google Scholar] [CrossRef] [Green Version]
- David, B.V. Chapter 10– Pseudomonas fluorescens: A Plant-Growth-Promoting Rhizobacterium (PGPR) With Potential Role in Biocontrol of Pests of Crops. Crop. Improv. Through Microb. Biotechnol. 2018, 221–243. [Google Scholar] [CrossRef]
- Maleki, M.; Mostafaee, S.; Mokhtarnejad, L.; Farzaneh, M. Characterization of’Pseudomonas fluorescens’ Strain CV6 Isolated from Cucumber Rhizosphere in Varamin as a Potential Biocontrol Agent. Aust. J. Crop. Sci. 2010, 4, 676–683. [Google Scholar]
- Gopalakrishnan, S.; Srinivas, V.; Prakash, B.; Sathya, A.; Vijayabharathi, R. Plant growth-promoting traits of Pseudomonas geniculata isolated from chickpea nodules. 3 Biotech 2015, 5, 653–661. [Google Scholar] [CrossRef] [PubMed] [Green Version]
- Uzair, B.; Kausar, R.; Bano, S.A.; Fatima, S.; Badshah, M.; Habiba, U.; Fasim, F. Isolation and Molecular Characterization of a Model Antagonistic Pseudomonas aeruginosa Divulging In Vitro Plant Growth Promoting Characteristics. BioMed Res. Int. 2018, 2018, 6147380. [Google Scholar] [CrossRef] [Green Version]
- Prasannath, K. Plant defense-related enzymes against pathogens: A review. AGRIEAST J. Agric. Sci. 2017, 11, 38. [Google Scholar] [CrossRef]
- Zhao, Y.; Tu, K.; Shao, X.; Jing, W.; Su, Z. Effects of the yeast Pichia guilliermondii against Rhizopus nigricans on tomato fruit. Postharvest Biol. Technol. 2008, 49, 113–120. [Google Scholar] [CrossRef]
- Anand, T.; Chandrasekaran, A.; Kuttalam, S.; Raguchander, T.; Prakasam, V.; Samiyappan, R. Association of some plant defense enzyme activities with systemic resistance to early leaf blight and leaf spot induced in tomato plants by azoxystrobin and Pseudomonas fluorescens. J. Plant Interact. 2007, 2, 233–244. [Google Scholar] [CrossRef]
- Ethan, A.; Shaukat, A.; Emmanuel, B.; Yang, Y.; Madhav, N. Disease Resistance Mechanisms in Plants. Genes 2018, 9, 339. [Google Scholar]
- Chen, F.; Wang, M.; Zheng, Y.; Luo, J.; Yang, X.; Wang, X. Quantitative changes of plant defense enzymes and phytohormone in biocontrol of cucumber Fusarium wilt by Bacillus subtilis B579. World J. Microbiol. Biotechnol. 2010, 26, 675–684. [Google Scholar] [CrossRef]
- Takishita, Y.; Charron, J.B.; Smith, D.L. Biocontrol Rhizobacterium Pseudomonassp. 23S Induces Systemic Resistance in Tomato (Solanum lycopersicum L.) Against Bacterial Canker Clavibactermichiganensis subsp. michiganensis. Front. Microbiol. 2018, 9, 2119. [Google Scholar] [CrossRef]
- Jasem, A.M.; Sharifi, R.; Abbasi, S. Induced systemic resistance to wheat take-all disease by probiotic bacteria. J. PlantProtection Res. 2018, 58, 304–310. [Google Scholar]

| Treatment | Disease Incidence (%) | Disease Index | Control Efficacy (%) |
|---|---|---|---|
| CK | 64.29 ± 0.72 b | 51.59 ± 1.11 b | |
| YB-10 | 0.07 ± 0.00 c | 6.67 ± 0.28 c | 87.07 ± 0.54 a |
| Ggt inoculation | 92.86 ± 0.62 a | 78.57 ± 0.47 a | |
| YB-10 + Ggt inoculation | 0.07 ± 0.00 c | 7.14 ± 0.11 c | 86.16 ± 2.23 a |
| Treatment | Root Fresh Weight (g) | Shoot Fresh Weight (g) | Shoot Length (cm) |
|---|---|---|---|
| CK | 0.91 ± 0.02 b | 1.18 ± 0.07 b | 8.21 ± 0.42 b |
| YB-10(109 CFU/mL) | 0.89 ± 0.03 b | 1.17 ± 0.01 b | 8.255 ± 0.37 b |
| YB-10(108 CFU/mL) | 1.51 ± 0.05 a | 1.72 ± 0.04 a | 12.43 ± 0.67 a |
| YB-10(107 CFU/mL) | 1.53 ± 0.03 a | 1.68 ± 0.06 a | 12.41 ± 0.52 a |
Publisher’s Note: MDPI stays neutral with regard to jurisdictional claims in published maps and institutional affiliations. |
© 2021 by the authors. Licensee MDPI, Basel, Switzerland. This article is an open access article distributed under the terms and conditions of the Creative Commons Attribution (CC BY) license (https://creativecommons.org/licenses/by/4.0/).
Share and Cite
Xu, W.; Xu, L.; Deng, X.; Goodwin, P.H.; Xia, M.; Zhang, J.; Wang, Q.; Sun, R.; Pan, Y.; Wu, C.; et al. Biological Control of Take-All and Growth Promotion in Wheat by Pseudomonas chlororaphis YB-10. Pathogens 2021, 10, 903. https://doi.org/10.3390/pathogens10070903
Xu W, Xu L, Deng X, Goodwin PH, Xia M, Zhang J, Wang Q, Sun R, Pan Y, Wu C, et al. Biological Control of Take-All and Growth Promotion in Wheat by Pseudomonas chlororaphis YB-10. Pathogens. 2021; 10(7):903. https://doi.org/10.3390/pathogens10070903
Chicago/Turabian StyleXu, Wen, Lingling Xu, Xiaoxu Deng, Paul H. Goodwin, Mingcong Xia, Jie Zhang, Qi Wang, Runhong Sun, Yamei Pan, Chao Wu, and et al. 2021. "Biological Control of Take-All and Growth Promotion in Wheat by Pseudomonas chlororaphis YB-10" Pathogens 10, no. 7: 903. https://doi.org/10.3390/pathogens10070903
APA StyleXu, W., Xu, L., Deng, X., Goodwin, P. H., Xia, M., Zhang, J., Wang, Q., Sun, R., Pan, Y., Wu, C., & Yang, L. (2021). Biological Control of Take-All and Growth Promotion in Wheat by Pseudomonas chlororaphis YB-10. Pathogens, 10(7), 903. https://doi.org/10.3390/pathogens10070903
